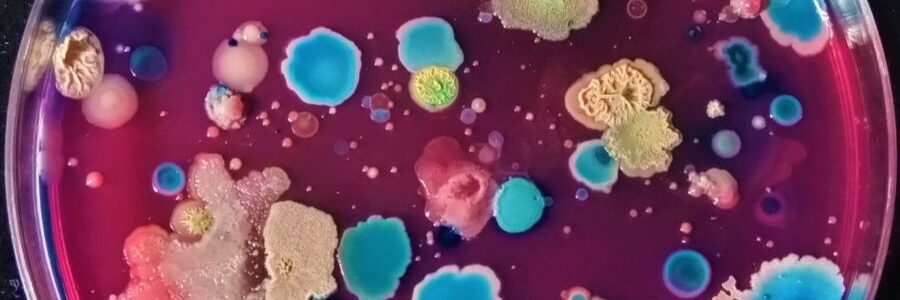

El evento reunirá el próximo 12 de marzo en el Palacio Euskalduna a instituciones, clientes y agentes del sector que repasarán juntos su trayectoria y retos de futuro.
Conectado al site
Revista medio ambiente
Residuos Profesional
Para la ciudadanía en general, la palabra residuo tiene unas claras connotaciones negativas, relacionadas normalmente con términos como basura y contaminación. Sin embargo, para los que conocemos este sector y hemos trabajado en él, hablar de residuos es hablar de cosas como industria, empleo, nuevos materiales, innovación, generación de riqueza, energías renovables, protección del medio ambiente y mucho más. Esta es la percepción que queremos difundir a través de esta web. Si quieres colaborar con tus comentarios y opiniones date de alta.